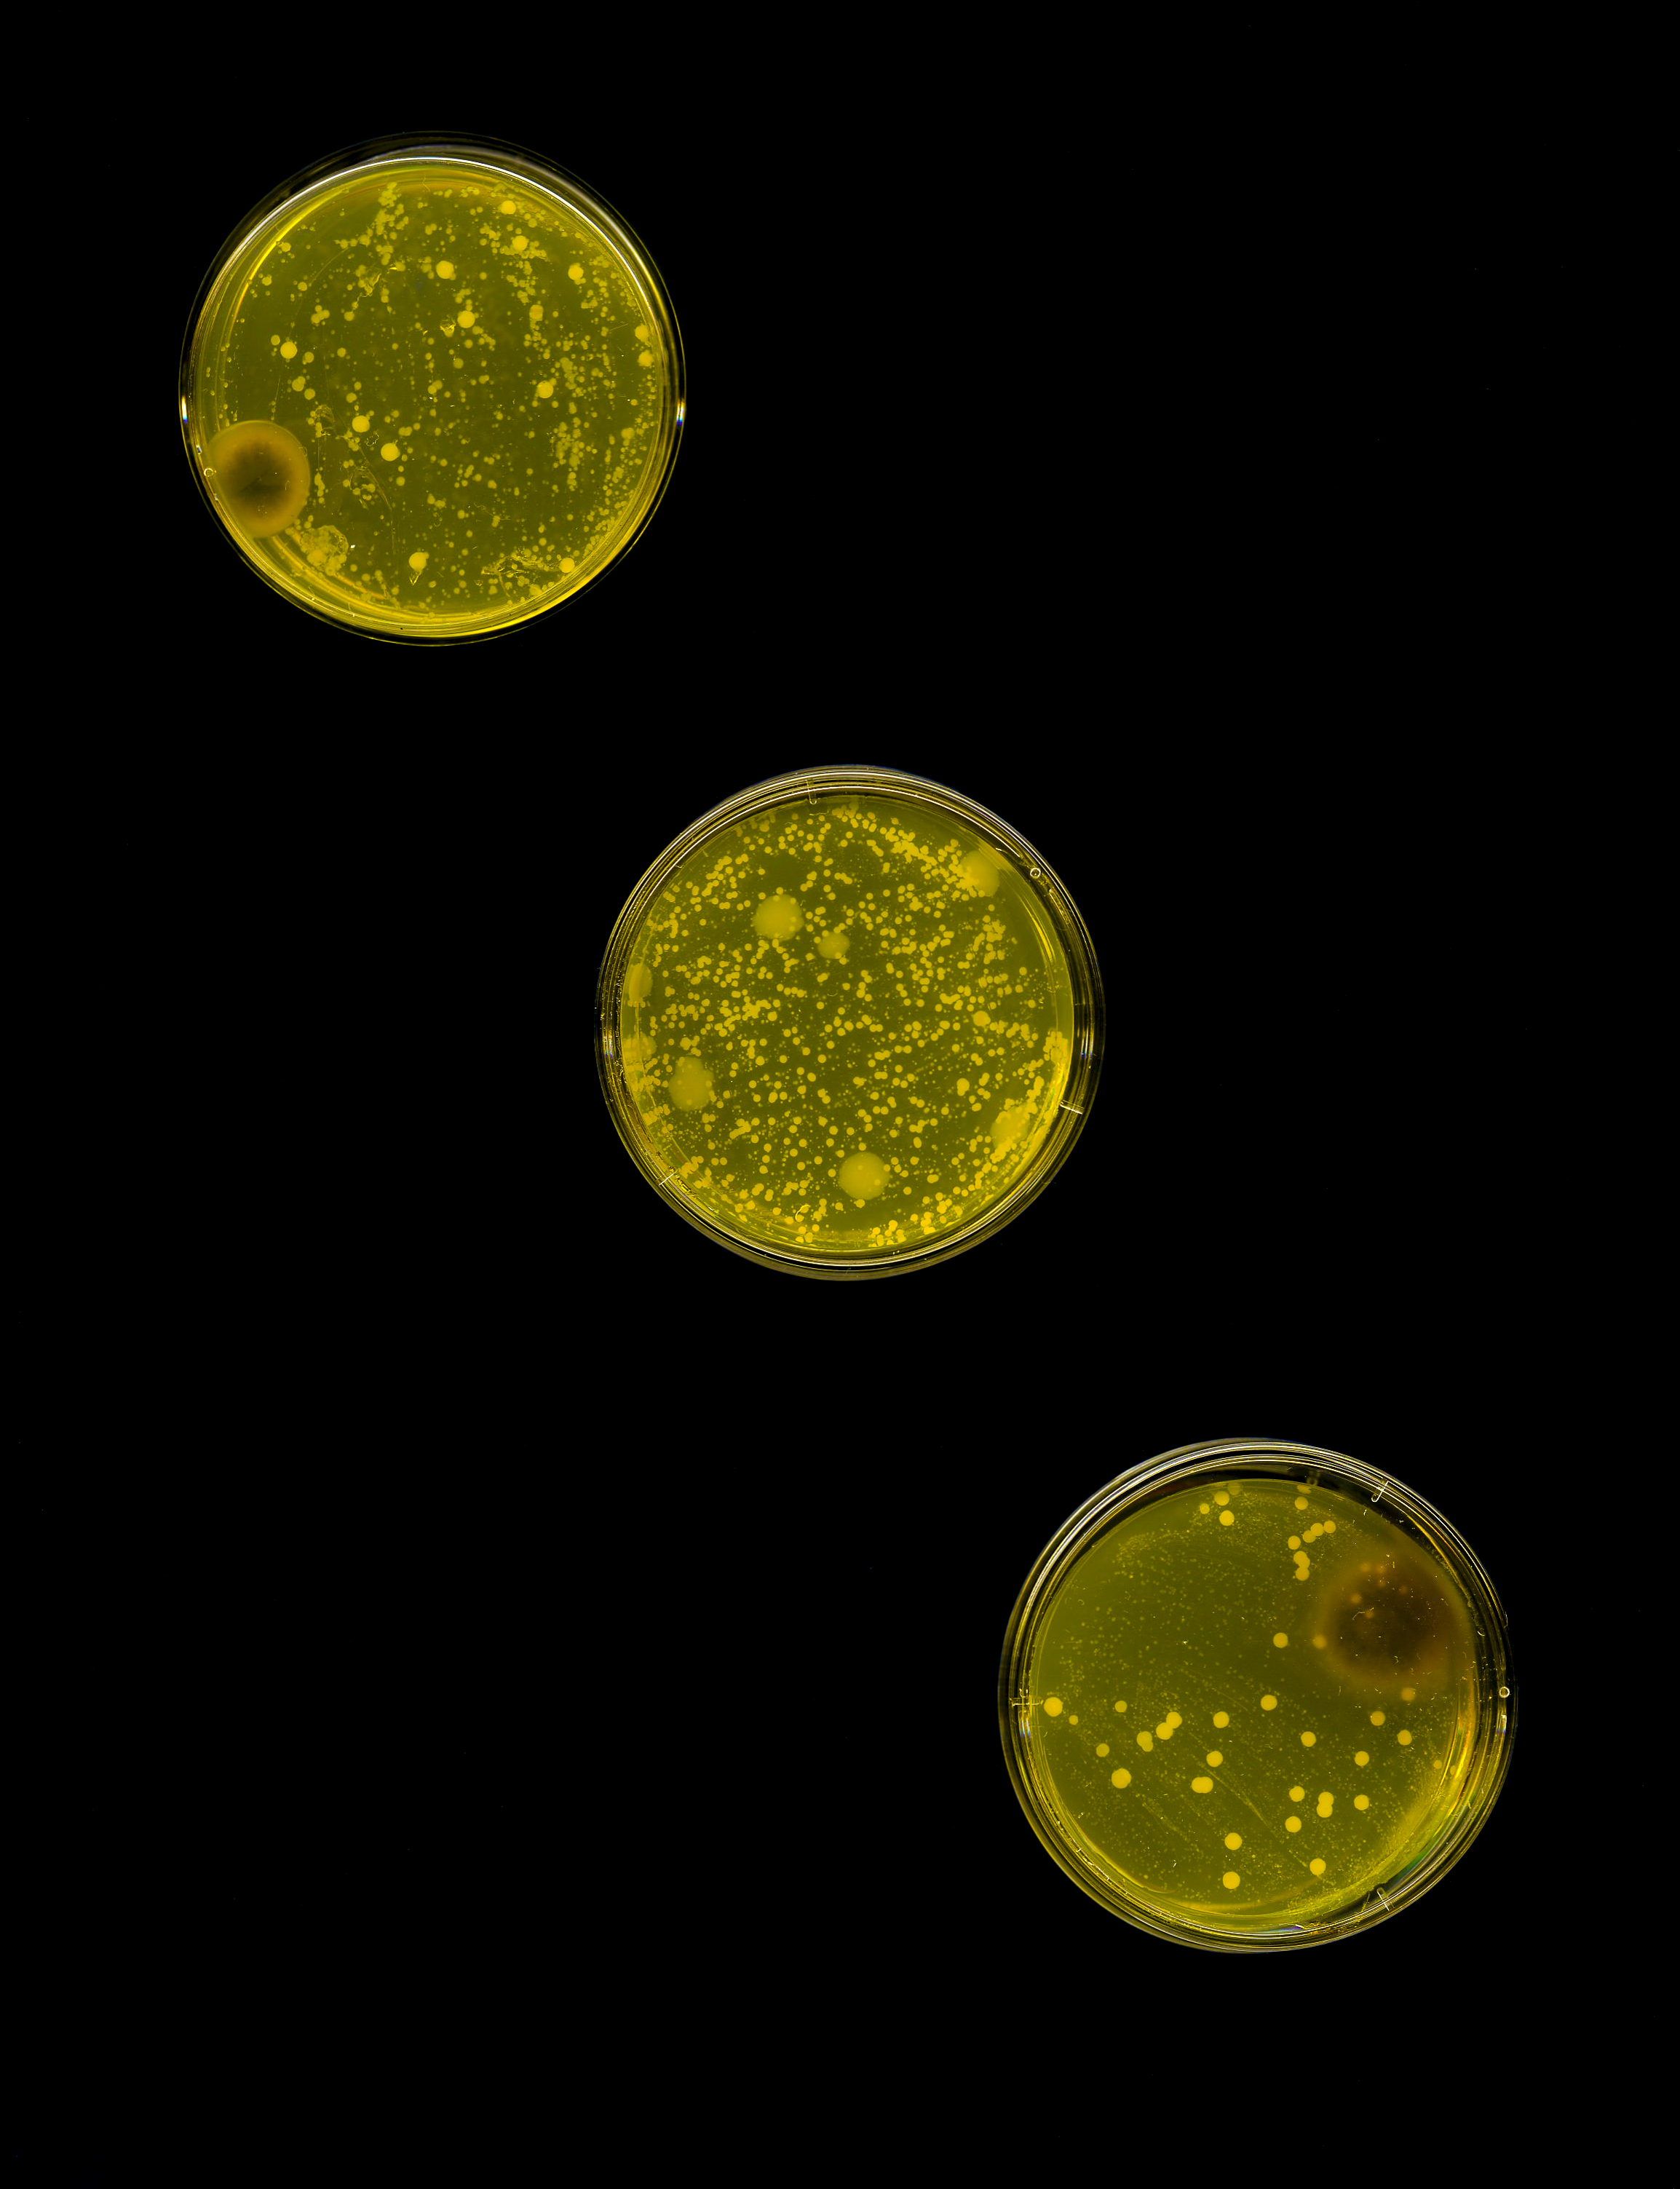
CaitlinAllen_251201_TheresBeautyintheBreakdown__003.png

My practice navigates the intersection of the clinical body and the natural world through a hybrid of scanography and cyanotypes.
I catalog the physical weight of medical treatment by scanning personal artifacts, from dental casts and medications to bacterial cultures, alongside the organic decay of animal bones.
Complementing this forensic approach, my cyanotypes explore resilience through the lens of collapse: reframing decomposition, mutation, and medical intervention as evidence of the body's ongoing negotiation with existence rather than its defeat. By layering medical imaging with botanicals in my cyanotypes, I aim to recontextualize the sterile diagnostics of illness into something intimate and tangible.